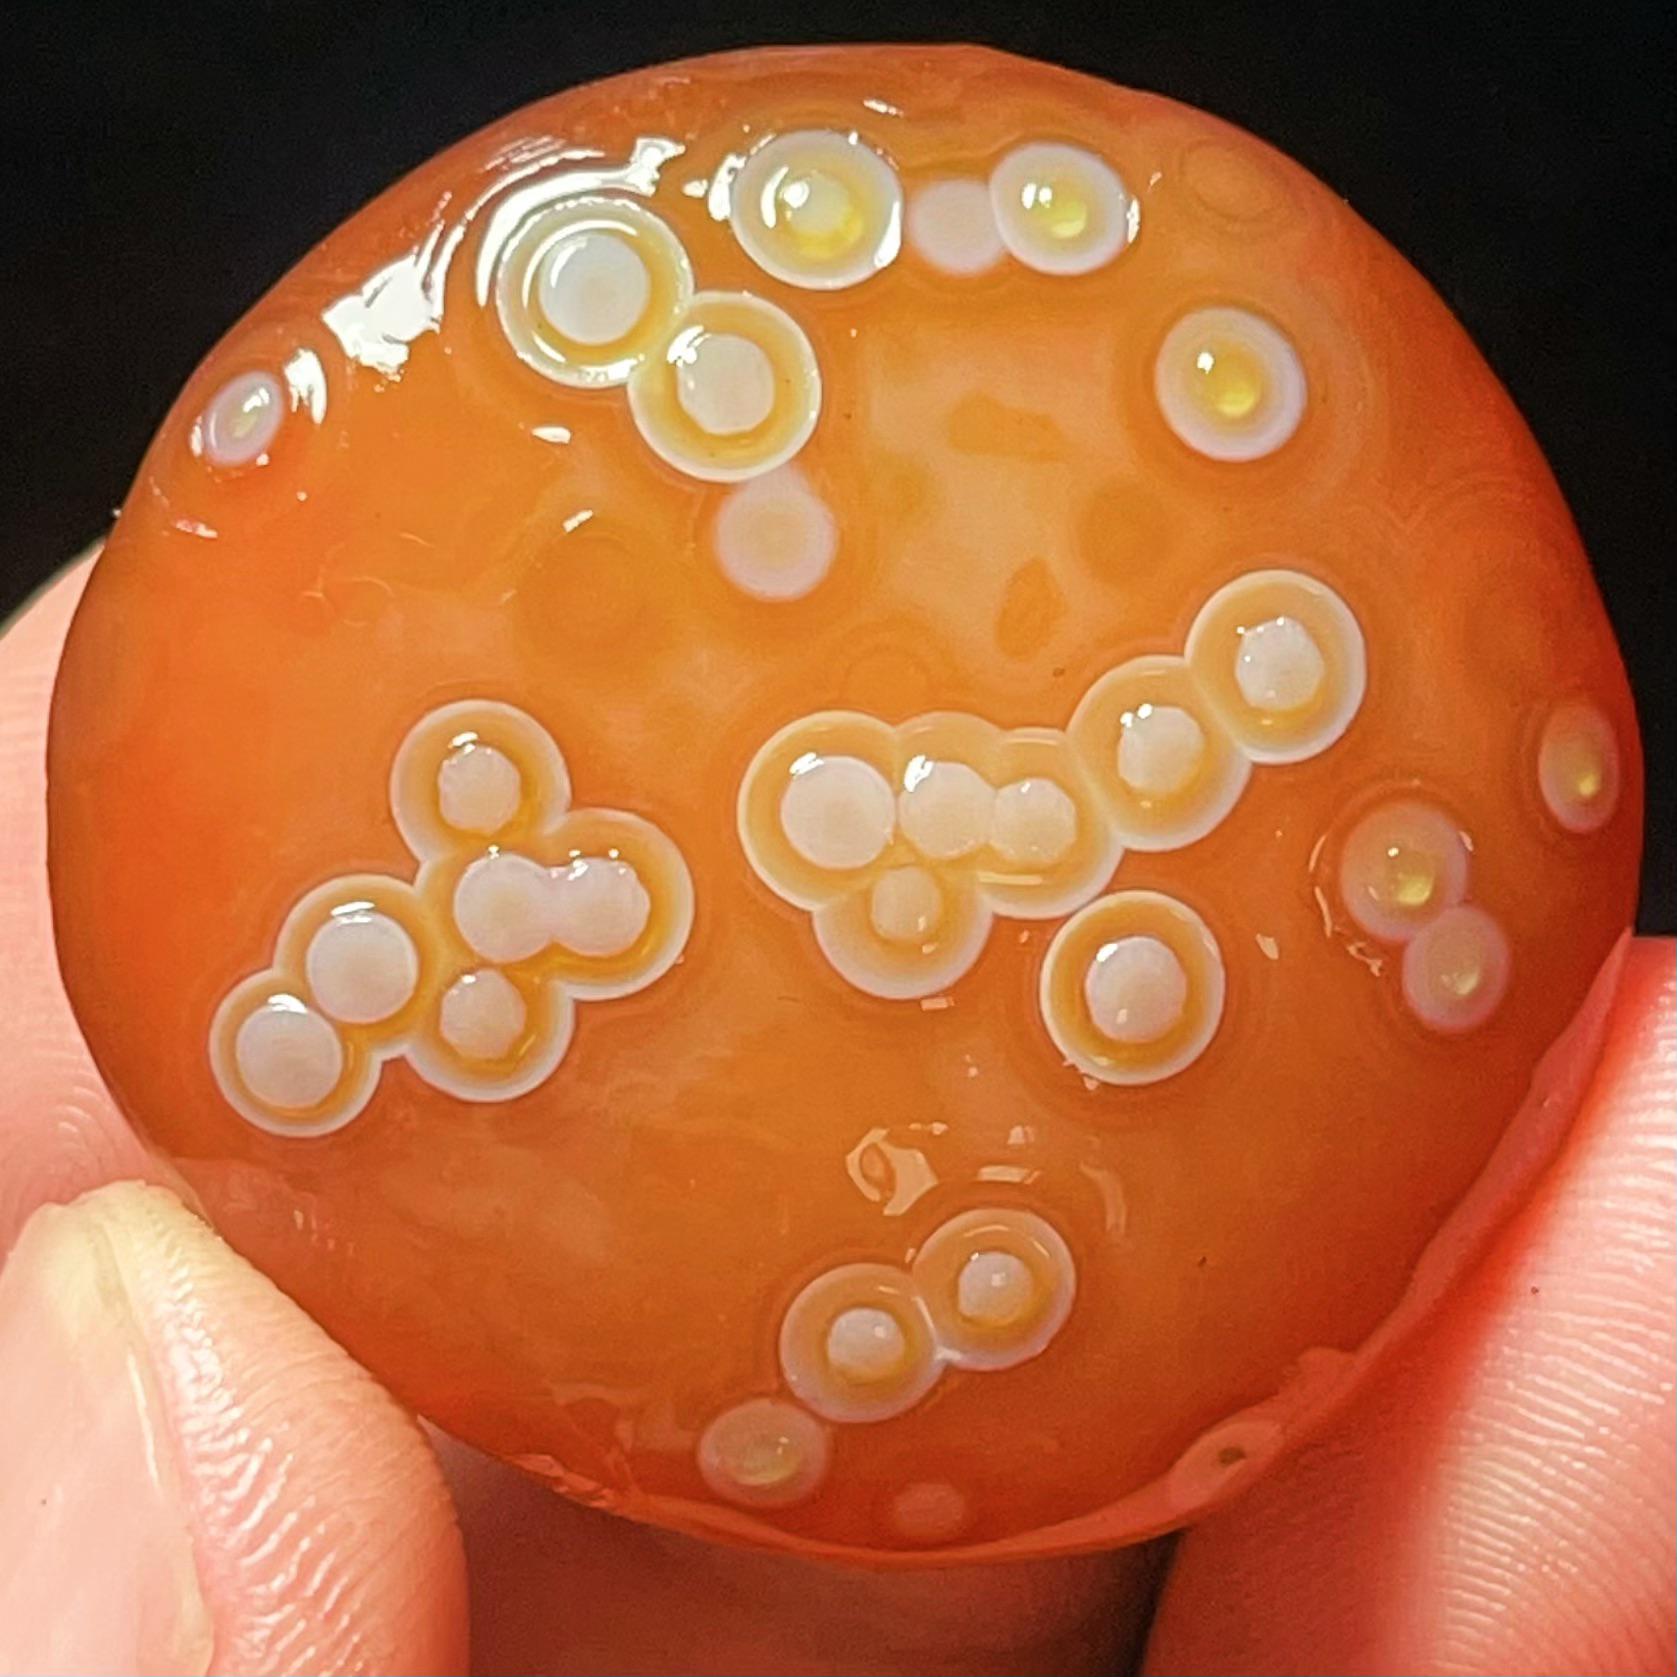
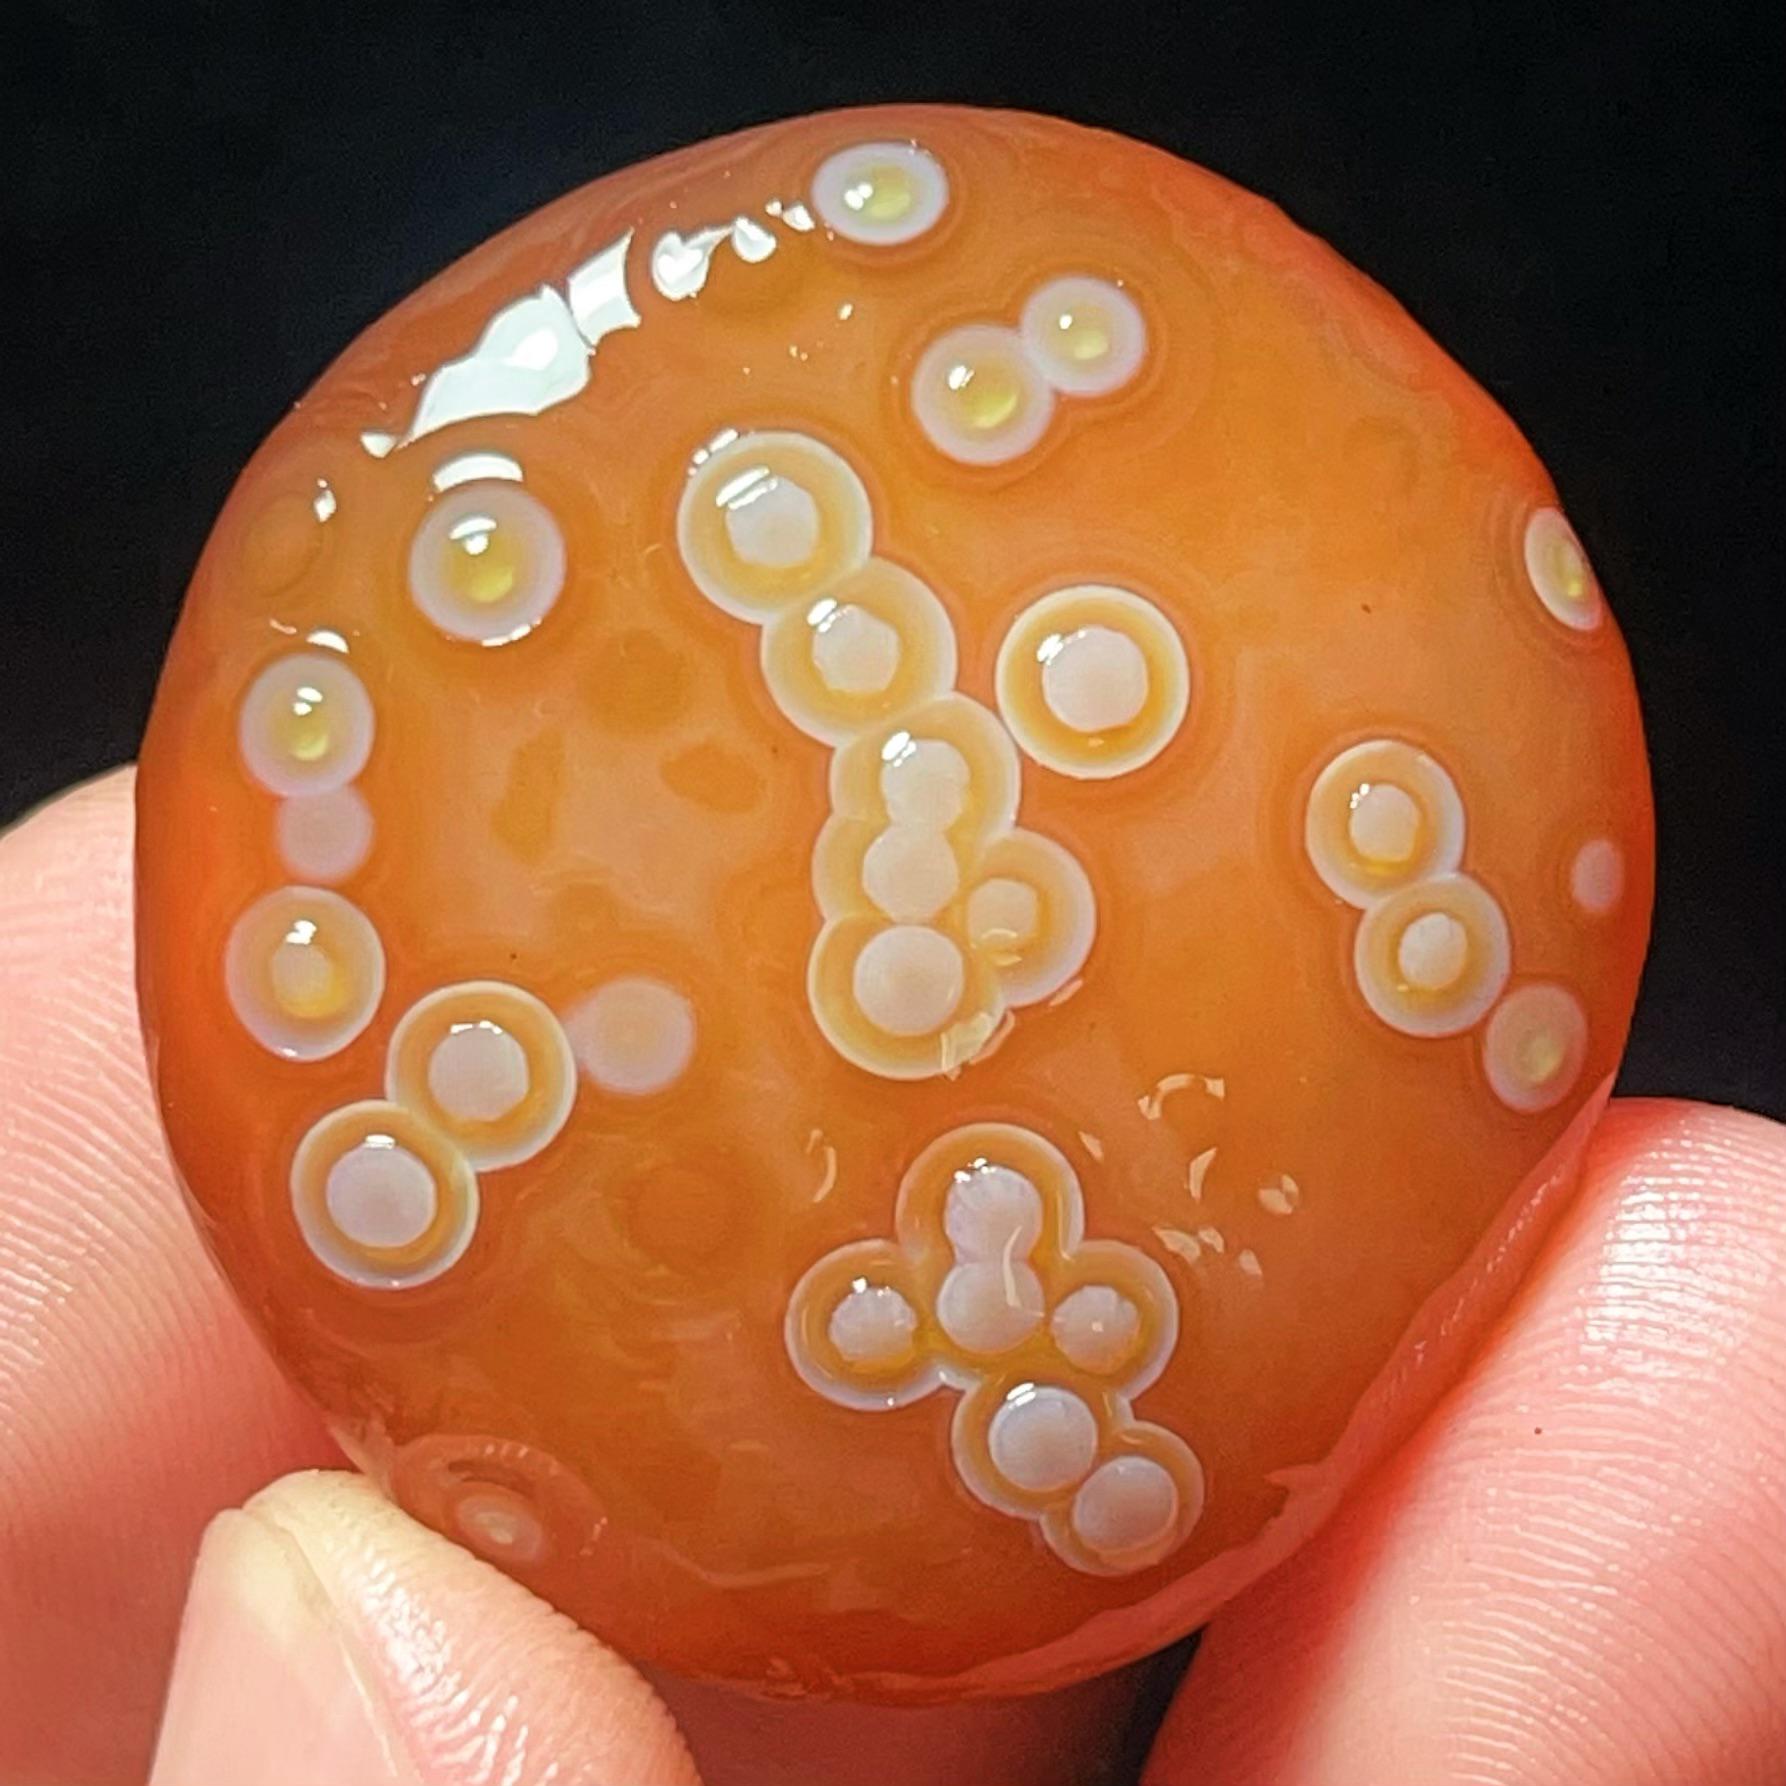
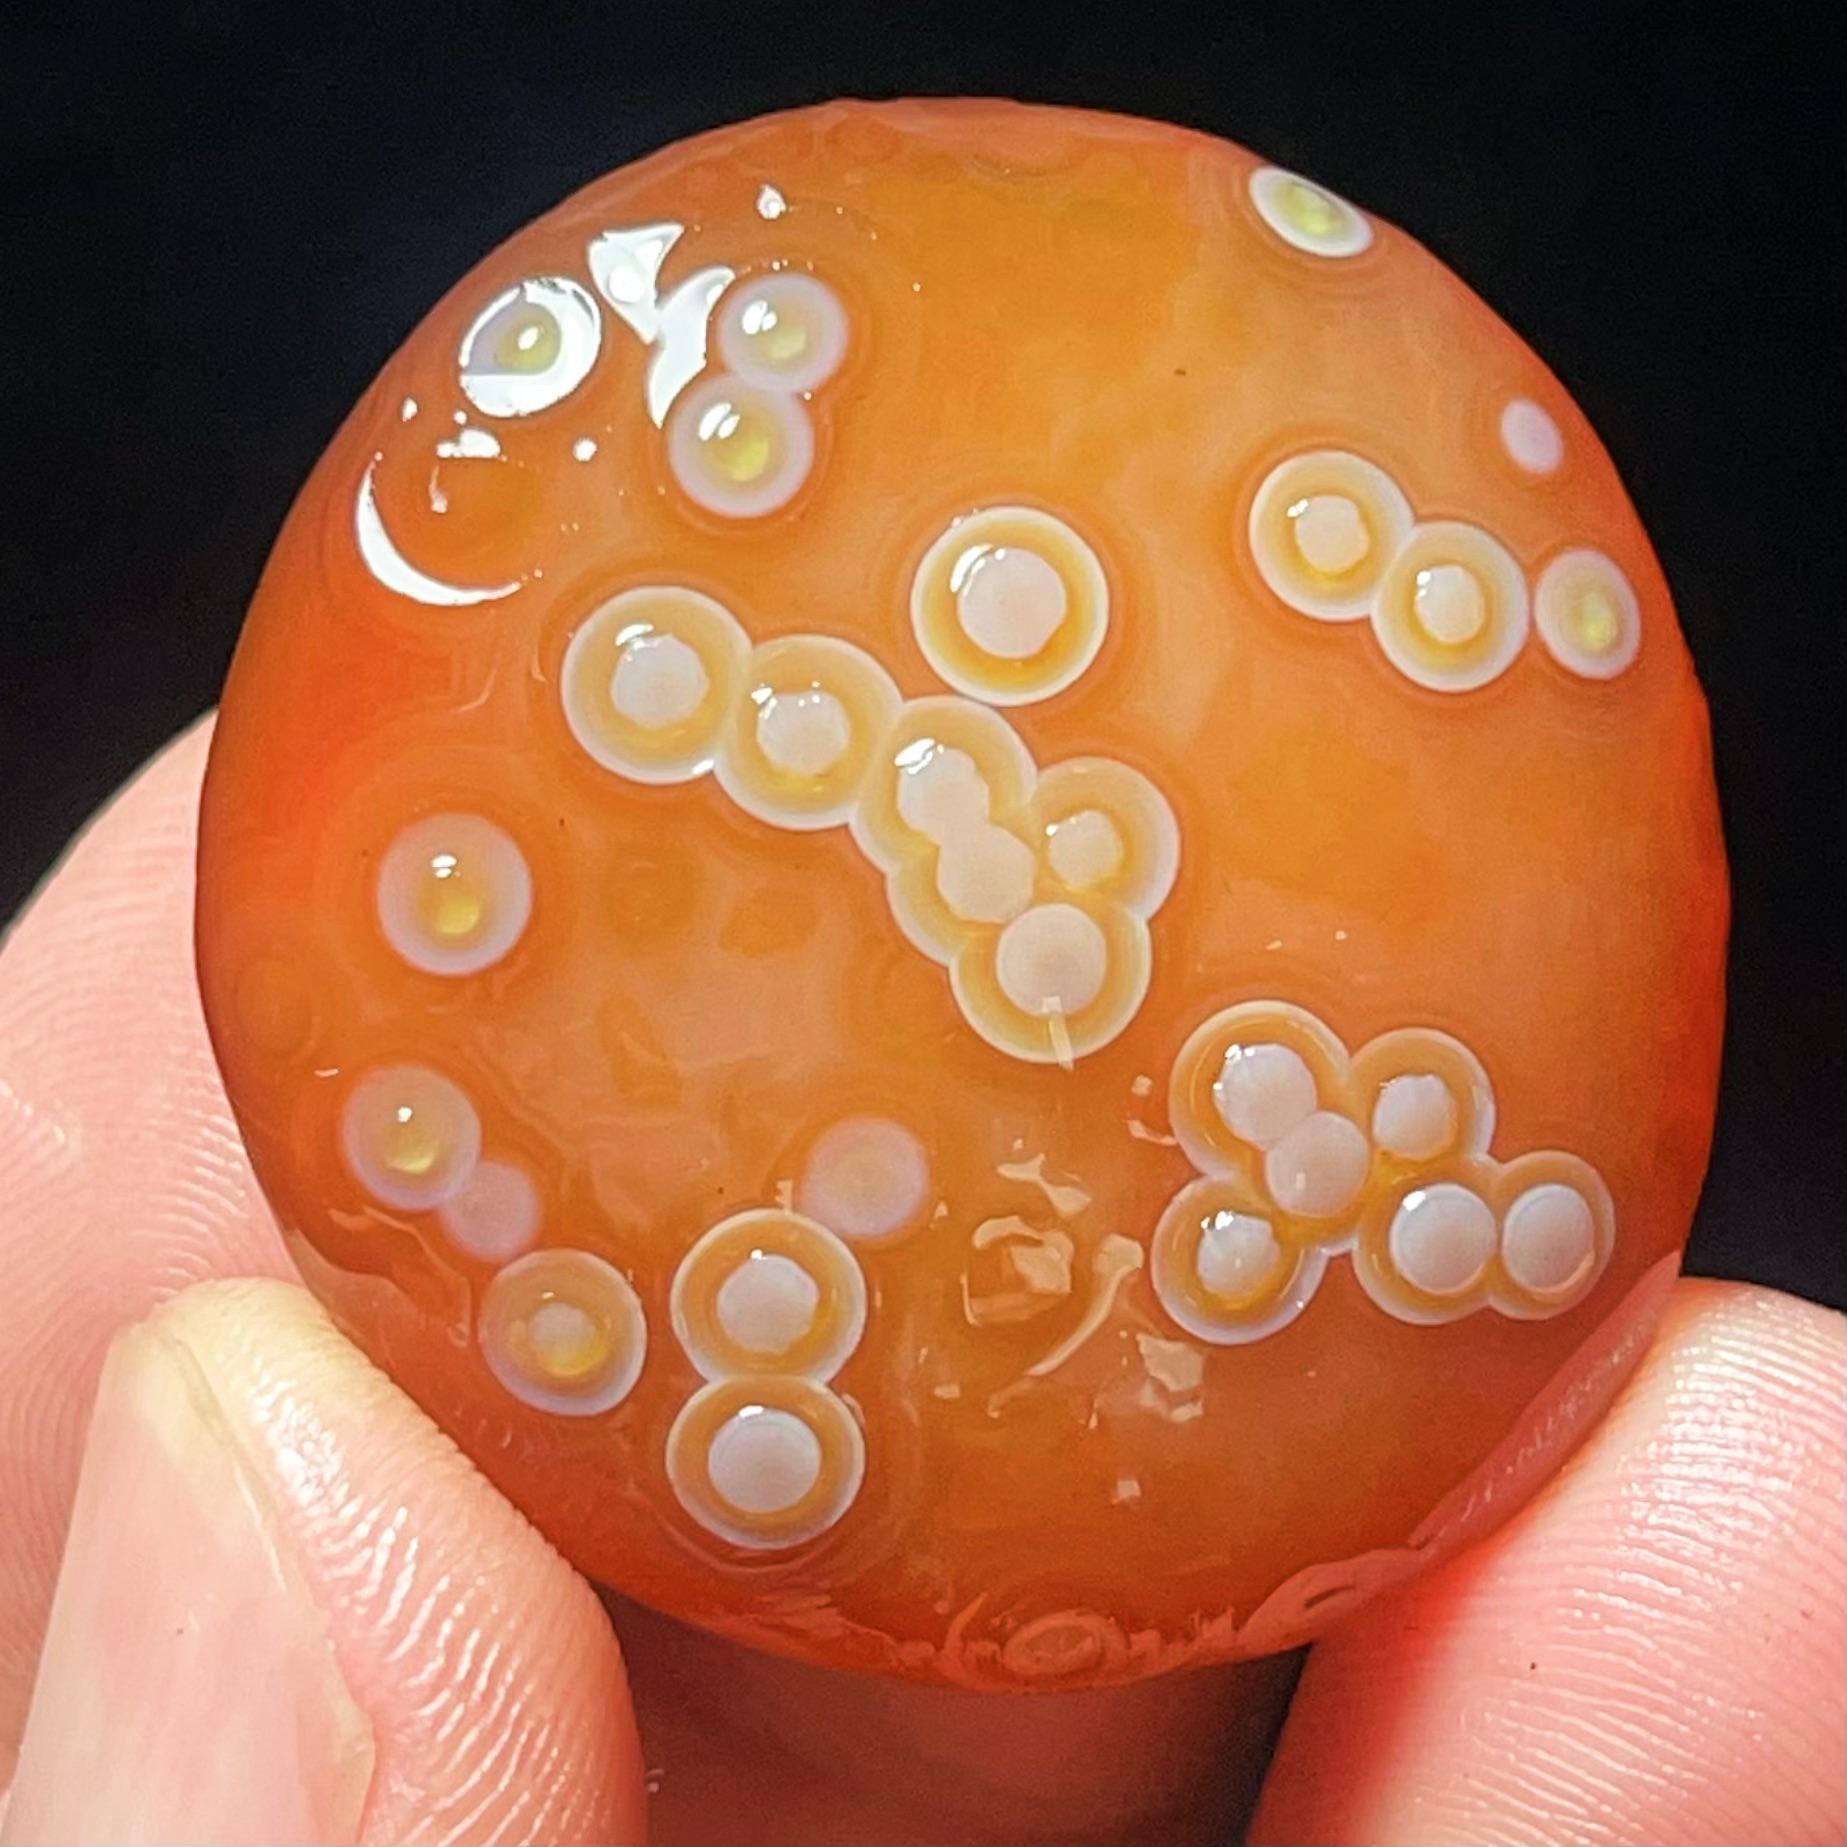
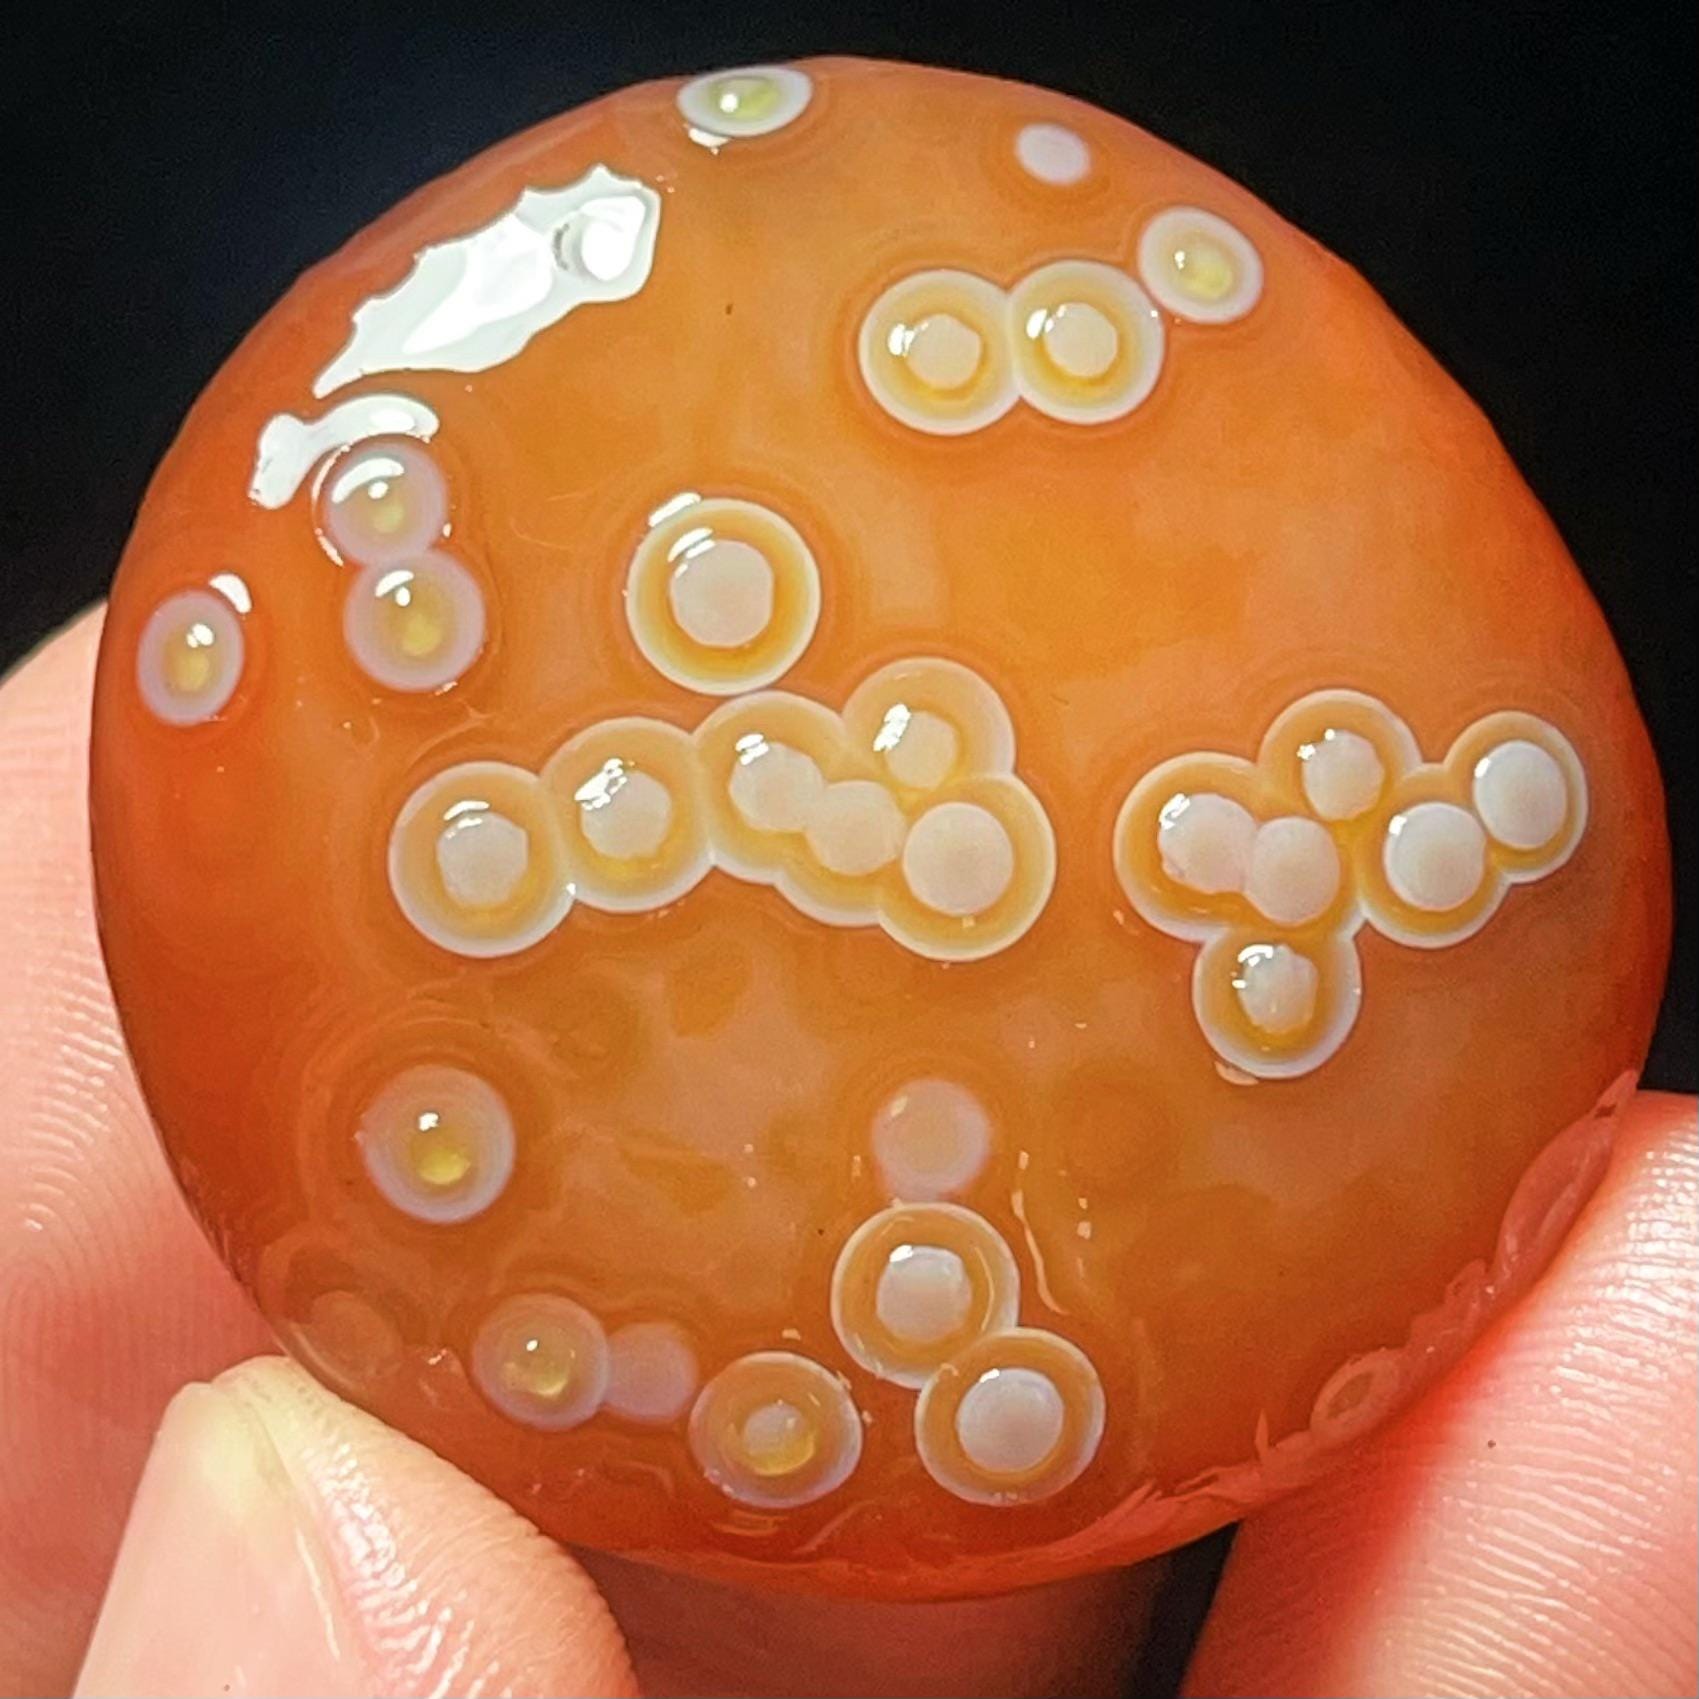

Gobi Eye Agate
Gobi Agate Eye Specimen: Energy Stone, Crystal Collection
$44.00 $55.00
-
DetailsDescription:
-100% Brand new and high quality
-Handmade Carved
-It is good gift for your friends,families
-Throughout every time and civilization known to mankind, Crystals and Gemstones have been said to hold special properties and power within them.
Specificatioin:
The one you see in the photo is the exact one you will receive.
Shape: specimen
Size(mm): 36*33*12 mm
Weight: 19g
Quantity: 1 point
1 in=25.4 mm
1 lb=453.59g
Note:
You get the same thing as the picture.
The color may also have some difference with the product,it is normal.
The pictures often look larger than real product,pls refer the product size.
If you mind these,pls don't place an order,thank you for your assistance!
If you want to see more goods, please click here.
https://therockland.etsy.com
This item can be used as a Special art decoration for your home ,office or business, or as a special gift.
If you need other size,please contact us,any size can be customized.
Shipping
Item will be shipped 2-3 work days after payment is received, unless otherwise stated in the listing.
All international shipments are made as registered mail, which includes a tracking number.
The shipping needs your telephone number,please leave it in the note when you place a order.
Customs and import taxes
Buyers are responsible for any customs and import taxes that may apply. I'm not responsible for delays due to customs.The shipping needs your telephone number,please leave it in the note when you place a order. -
Shipping & Policies
Shipping from China
Processing time
1-2 business days
Customs and import taxes
Buyers are responsible for any customs and import taxes that may apply. I'm not responsible for delays due to customs.
Payment Options
Returns & Exchanges
I don't accept returns, exchanges, or cancellations
But please contact me if you have any problems with your order.
Frequently Asked Questions
Wholesale availability
Accept wholesale,Hand-carved custom.Please contact me before placing your order.




